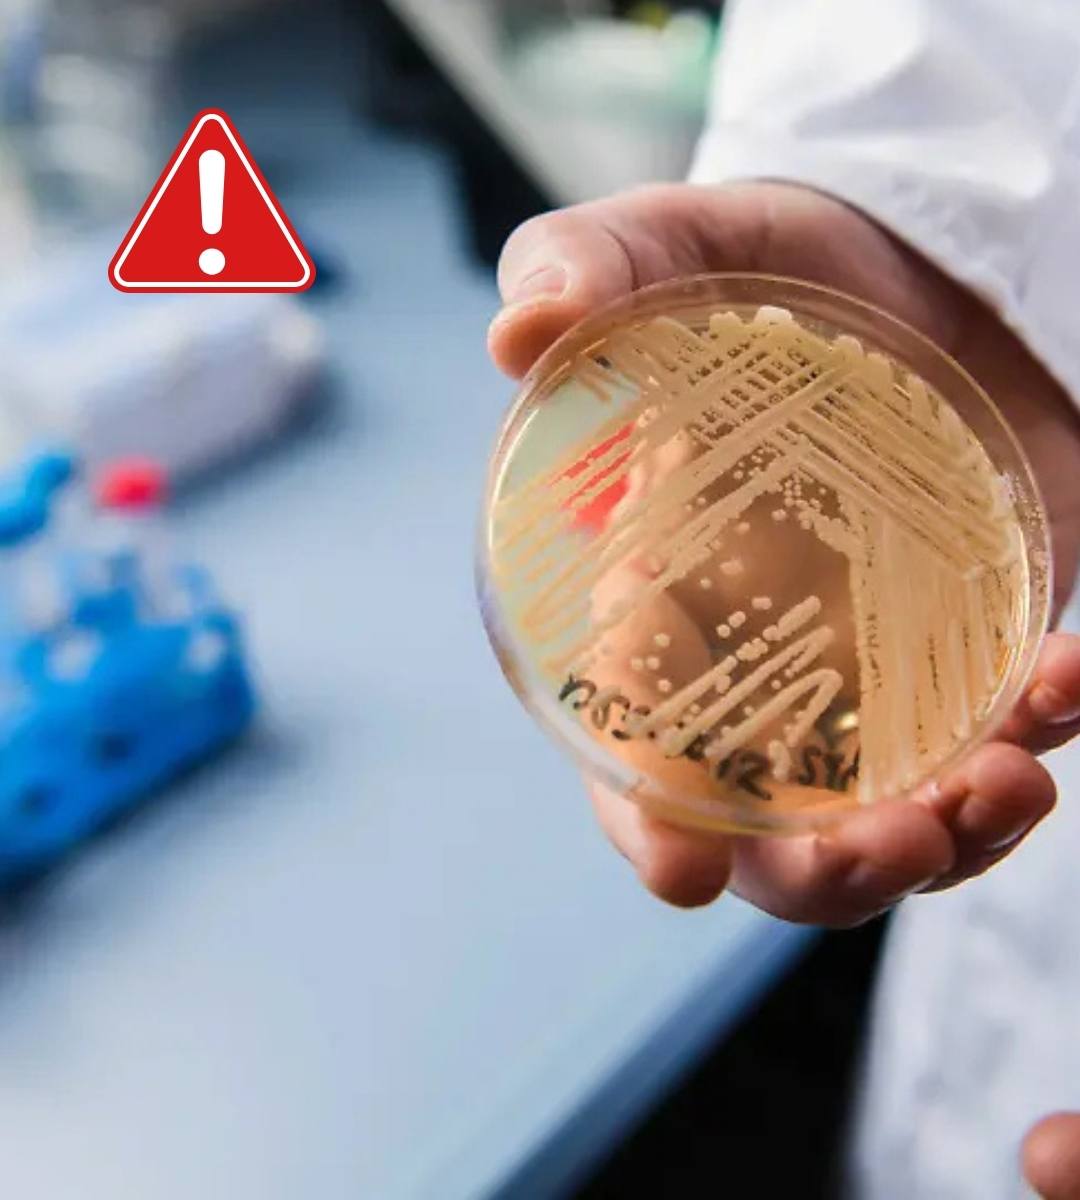

O ciupercă mortală face ravagii în spitalele europene. Un nou tip de ciupercă patogenă, Candidozyma auris – cunoscută anterior drept Candida auris – se extinde rapid în spitalele din Europa și începe să provoace îngrijorare în rândul medicilor microbiologi. Identificată pentru prima dată în 2009 în Japonia, ciuperca s-a dovedit a fi extrem de contagioasă, rezistentă la numeroase medicamente și capabilă să supraviețuiască luni sau chiar ani pe suprafețe din spitale.

O ciupercă mortală face ravagii în spitalele europene
Potrivit unui nou raport al ECDC, între 2013 și 2023 au fost confirmate aproximativ 4.000 de cazuri în țările UE și EEA. Germania a raportat 120 de cazuri, peste jumătate numai în 2023. Cele mai mari focare se află în Spania, Grecia, Italia și România, unde lipsa unei monitorizări sistematice sugerează o cifră reală mult mai mare. scrie n-tv.de. Specialiștii avertizează că pacienții care ajung în spitale din sudul Europei se pot întoarce în țara de origine purtând ciuperca fără să știe. De ce? Pentru că aceasta se transmite prin contact indirect – de pe pielea unui pacient pe altul, adesea prin intermediul personalului medical sau al aparaturii.
Candidozyma auris nu se transmite prin aer, ca virusurile respiratorii, dar poate rămâne activă pe echipamente medicale greu de dezinfectat: sonde de temperatură, spatule folosite pentru bronhoscopii, proteze sau diverse instrumente reutilizabile.
Citește și: Primul om ucis de noua gripă aviară H5N5 – medicii vorbesc despre „un virus imprevizibil”
De ce este atât de periculoasă?
- supraviețuiește mult timp pe suprafețe
- dezvoltă biofilme care o protejează de sistemul imunitar și de tratamente
- este adesea rezistentă la antifungicele obișnuite
- poate provoca infecții severe, inclusiv sepsis, mortal în aproape 50% din cazuri la pacienții vulnerabili
Persoanele cu risc crescut includ:
- pacienți proaspăt operați
- vârstnici
- bebeluși prematuri
- persoane cu imunitate slăbită sau boli cronice (dializă, cancer etc.)
Simptomele pot lipsi cu totul. Mulți purtători nu prezintă simptome, motiv pentru care ciuperca se poate răspândi ani întregi fără a fi depistată. Infecțiile apar atunci când sistemul imunitar cedează, moment în care pot apărea febră mare, frisoane sau infecții grave ale rănilor.
Igiena mâinilor, arma principală
Experții de la RKI subliniază că prevenția începe cu o regulă simplă, dar crucială: igiena mâinilor în spitale. Transferul se produce frecvent prin personal medical. Pentru dezinfectarea mâinilor sunt recomandate soluții alcoolice, iar pentru suprafețe — dezinfectanți pe bază de clor. Unele substanțe, precum clorhexidina, s-au dovedit insuficiente în anumite focare din Marea Britanie.
În timp ce în SUA și India există deja tulpini complet rezistente la antifungice, situația din Germania rămâne sub control. Majoritatea cazurilor sunt încă tratabile, iar noi medicamente antifungice sunt în faze avansate de testare clinică. „Nimeni nu trebuie să intre în panică”, afirmă experții. Dar răspândirea trebuie încetinită cât mai mult. În prezent, ciuperca trebuie raportată în Germania doar atunci când provoacă boală. Dar pentru că se răspândește deja înainte de apariția simptomelor, specialiștii recomandă obligativitatea raportării tuturor cazurilor depistate.
